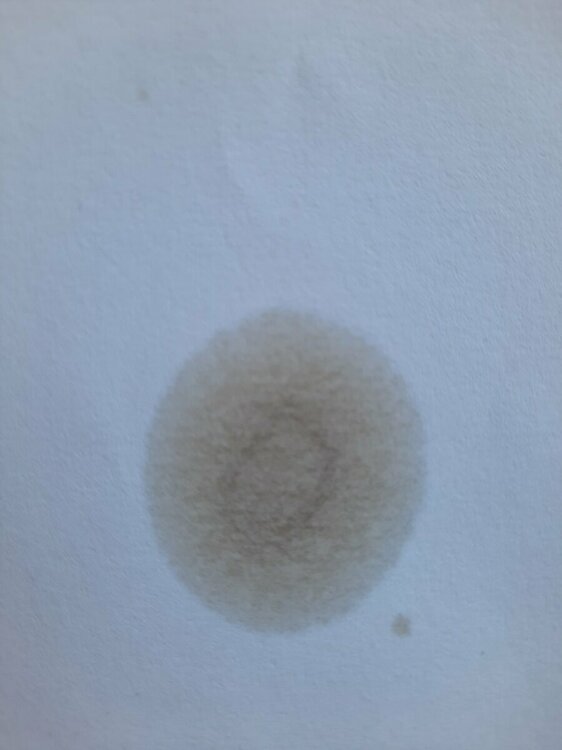

-
Sporočil
1.785 -
Z nami že
-
Nazadnje prisoten
-
Dnevne zmage
30
Tip vsebine
Profili
Forumi
Koledar
Garaže
Vse objave uporabnika scania
-
Mogoče pa se doba mazde 6 nadaljuje.
-
Jaz menjam vsako leto na obeh baterijo ko delam servis in pa sam kljuc tako da je eno leto eden v uporabi drugo leto pa drugi, pol pa spet menjam.
-
To je super poraba. Pri toyoti corolli cross hybrid se pricakuje okoli 5,5 baje. Ampak glede na cx30 pa ni hybrid je za razmislit. Res je da pri hybridu na mestni vožnji prišparaš. Ta poraba je super.
-
Pri 6ki bi prej prisel v Dubrovnik kot pa da ohladi s 40 na 24. Me veseli da so v cx30 zadevo porihtali 🙂
-
Klima v mazdi je ena najslabših, moje mnenje. Dela zelo slabo, v m6 poleti ne sfolga konkretno hladit na 24, tako da moraš pustit na notranje kroženje če želiš da ohladiš vozilo, v momentu ko preklopiš na zunanji zrak kar čutiš da ne sfolga. Vglavnem zelo bogo, druge znamke imajo to 100x bolje porihtano. Primer toyote vklopis npr na 24 se vklopi notranje krozenje zraka za 10 do 15min v tem času čutiš da hladi (pri mazdi je obcutek kot da bi pri 40stopinjah gledal leden pir skoz šipo) potem se izklopi samodejno notranje kroženje, ventilator pojaca za eno stopnjo in vzdrzuje temp brez tezav. Za mazdo sem pa tudi na servisu omenil od novega ene 4krat to hobi klimo in so sami potrdili da jih dosti jamra in da so svohne.
-
Michelin zagotavlja da je remix guma, nalita enakovredna novi nenaliti gumi. Tudi profil na pogonski gumi se lahko poglablja z rezanjem. Poanta je v ceni, torej guma je pol cenejša in zdrži enako okoli 250000km če gledamo pogonsko in jo potem še poglobiš si ji podaljšal življenjsko dobo še za max 100000km, pri 100kamionih pa se to že pozna. Primer katerega sem opisal je bilo z balonarko na prvi osi s tem da se je povozilo nek jeklen profil. Edino kaj opažamo da je remix pogonska michelin dosti bolj trda guma.
-
Smo pa imeli primer na kamionu 40ton 90tempomat, na prikolici razneslo, kot nic normalno vstavis, na prvi osi pa ga ni junaka ki vlovi, gre direktno s ceste pa lahko delas kaj ces. Od takrat zmeraj pri veliki hitrosti predvidevam, kaj pa ce... bog ne daj ampak kaj pa ce.... Tudi z letalom ko letim in razmisljma kaj pa ce motor odpove kje bom pristal.... Ziher je ziher.
-
Tak kot kamione vse zapret na 90km/h pa mir 🤣🤣🤣 To so pa zvani kamikaze.
-
To je res pri 130 bi se še malo mučil, pri 200 te pa v trenutku ni več.
-
Pa kdaj pomisliš da ti takrat guma poči? Samo vprašam za prijatla
-
Lepo bi bilo če bi avtor napisal kaj je sploh bilo, ne pa samo slike nalimal. Za vse tiste z zimskimi gumami poleti pa en predlog, dajte skocit z letala brez padala, mogoce se pa izide...
-

Zginja antifriz
scania je odgovoril na mazda gh-ovo teme v forumu Tehnične težave, vzdrževanje in stroški
Verjamem da nimas vec zaupanja v avto. Po eni strani si vlozil ogromno zivcev, denarja,casa, in vsega. Po drugi strani pa nimas vec zaupanja v avto. Enako se mi je zgodilo z mercedesom, potem sem raje menjal. Vcasih je to najboljsa opcija. Vse dobro ti zelim. -
Malo za primerjavo, v torek 16.8 (4mesece od nakupa) sem imel prvi servis na yarisu. Prevoženih je imel 11000km, do servisa je se bilo 4000km ampak zaradi slabe ocene stanja olja smo rajsi dali prej. Vglavnem menjali so olje 0w8 (njihovo olje original toyota) 3,6litra, oljni filter, klima filter, razkuzili klimo, pregled in test hybridnega sistema, pred izpustom olja so dodali aditiv za spiranje motorja, dodali aditiv za ciscenje sob, pregled vozila in probna voznja. Cena je bila 195€. Meni se zdi cena super.
-
Super se mi zdi poraba, glede na to kaksne razmere so bile na cesti. Pridi malo s hribov, je bolj gost zrak 😉😉
-
Tako pocasi pa ni slo. Skoz nihanje do 100 in na 60 pa spet na 100. Z tekoco voznjo bi lahko bila nizja, ceprav 6,2 se mi ne zdi slaba za povratek saj je kar nekaj vzpenjanja.
-
Poraba goriva na relacijo Crikvenica- izlet po Krku- Varazdin- Ormoz- Ptuj: 6,2 . Lahko bi bilo bolje ampak je bila nenormalna guzva in samo cijazenje, vglavnem nic od tekoce voznje. Meni se zdi super.
-
Grem se igrat, ker to zdaj neki core, plus, gt plus, pol pa še maš neki SO, SA .... cela abeceda hahahaha
-
Kaj se da komu napisat kako si sledijo opreme pri cx30 ker jaz nimam pojma, sem s tistih časov ko so bile opreme CE, TE, GTA, zdaj pa to vse neki GT plus pa neki sound itd itd.. če je komu za razložit. Hvala
-
Tocno tako, s predvidevanjem in cimbolj tekoco voznjo (brez rektalnih zapikavanj, kar obožujejo bmw fahrerji, sem prejsnji teden glih razmisljal da mora bit ogromno bmw voznikov gejev 🙃🙃🙃🙃). Bi pa res enkrat rad sprobal x186 motor na moj stil voznje, po moje bi enako turo zvozil s porabo 5
-
-
Jaz čakam novo corollo cross, me je yaris s porabo tako navdušil da sem začel razmišljat o menjavi, in glede karakteristik in izgleda mi je corolla cross najbližje ampak seveda prvo testna vožnja pol pa da vidimo.
-

Analiza olja z metodo kapljičnega vzorca
scania je odgovoril na Aless-ovo teme v forumu Tehnične težave, vzdrževanje in stroški
Hvala. Razmišljam da bi še poslal en vzorec 100ml novega 0w8 olja, da bi imel za primerjavo. Kaj misliš? -

Analiza olja z metodo kapljičnega vzorca
scania je odgovoril na Aless-ovo teme v forumu Tehnične težave, vzdrževanje in stroški
-

Analiza olja z metodo kapljičnega vzorca
scania je odgovoril na Aless-ovo teme v forumu Tehnične težave, vzdrževanje in stroški
Toyotin vzorec na nov papir, in meni zgleda dosti bolje kot prej. @Aless mnenje prosim. Sem sprobal prejsnji papir na tiskalniku in malo razliva print, tak da sumim da je bila neka huda sorta papirja prej kriva. Sem pa danes se za ziher en muster od mazde nardil. -

Analiza olja z metodo kapljičnega vzorca
scania je odgovoril na Aless-ovo teme v forumu Tehnične težave, vzdrževanje in stroški
Evo se vzorec z mazde g165 prevozenih 97000km 4000km od servisa olje mazda 5w30. Zdaj se mi zdi tudi kar nekaj goriva v olju, hmmmm kaj pa ce imam nek čuden papir? Ker zdaj mi je pa že nekaj sumljivo. Hmmmm @Aless prosim oceno. Hvala.